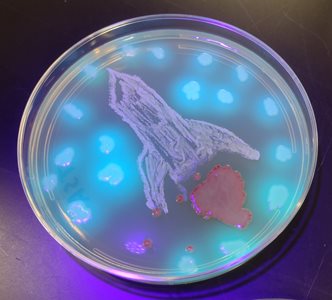
"Shapeship flying through the Stars" Agar Art image
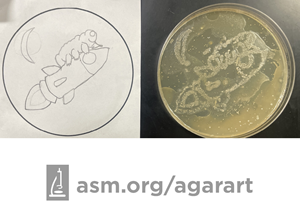
"The Rocket Bear" Agar Art image
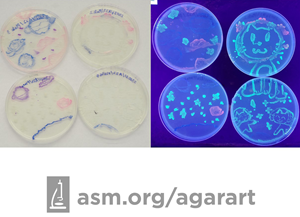
"Playing in the space" Agar Art image

ASM Agar Art Contest
All were creative and beautiful, but only a few could be chosen as the best. Check out the winners below, and find links to all entries at the bottom of each section. Unfortunately, due to irregularities in voting, we have decided to not award the People's Choice prizes this year.
Professional Category
1st Place (Overall Winner)
Alien Medley

One of the tantalizing questions of outer space is, “What would aliens look like?” They could be single-celled. They could be multi-cellular! There is no shortage of speculation in books and films, with only our imagination as the limit. The aliens depicted here are inspired by the “Yip Yip” aliens of Sesame Street and the little green men from the vending machine in the movie Toy Story. The bacteria used is Klebsiella pneumonia, a relative of E. coli that secretes a slimy capsule. Both capsulated and non-capsulated variants of K. pneumoniae were used to draw the aliens. The eyes are disks used for antibiotic susceptibility testing (with permanent marker pupils), and the colors of the agar are different indicator dyes from around the lab. Most of the dyes change color depending on the pH, but 1 of dyes (Resazurin) changes color in the presence of oxygen. If we were to meet aliens (and their microbiota), I hope they are as friendly and expressive as the ones drawn here.
2nd Place
Agarnaut

3rd Place
Microbial Perseverance

Creator Category
1st Place
A Cosmic Journey of Yeast Cells.

Imagine yeast, those remarkable microorganisms that bring life to our bread, beer and wine. Now, envision them embarking on a unique adventure beyond the confines of our planet. This is the captivating story that my Agar Art piece portrays—the incredible journey of yeast cells in the cosmos. In the vast expanse of space, scientists launched a small satellite called BioSentinel to explore how yeast cells respond to the rigors of space radiation and its effects on DNA repair mechanisms. My artwork depicts this extraordinary voyage. At its core, you'll find BioSentinel, a CubeSat adorned with solar panels, carrying the yeast cells into the great unknown. The spacecraft is surrounded by beautiful stars radiating different colours, symbolizing the vastness and beauty of space. To the left, I’ve also tried to depict the Moon to mimic deep space where this yeast carrying satellite will travel and unearth the potential of a living form to withstand space radiations.
This art piece not only celebrates the inquisitiveness of scientists who thought out of the box and sent yeast into the cosmos, but also prompts us to contemplate that, in the vastness of space, all life forms, no matter how small, have their place and can journey into the stars. It's a reminder of the boundless marvels of science and the incredible adventures that even the simplest life forms can embark upon.
2nd Place
Shapeship Flying Through the Stars
Spaceship flying through the stars. The medium used was tryptone soy agar and it was incubated at 21°C. The spaceship was made using Staphylococcus aureus, and the flame was made using Serratia marcescens. The stars were made using Pseudomonas auroginosa. The plate is shown illuminated with UV light.
3rd Place
The Birth of a Star

Somewhere in the universe, a new star has been born. We may learn about it tomorrow, or it could be a million years from now. The paths of stars and our lives intersect. Just contemplating it fills the heart with wonder. I expressed the blessing of the birth of a new star and its surging energy in blue produced by Candida tropicalis.
Open Category
1st Place
Irradiating Microbes

2nd Place
Space Traveling Microbes; Architects of Life
Microbes in space might sound surprising, but they play a big part in the story of life on Earth. Billions of years ago, these tiny adventurers hitched rides on space rocks, landing here and becoming the pioneers of life. Settling in oceans and soil, these microbes started the incredible journey of life, evolving and shaping the diverse forms we see today. They are like the original architects of life, turning a young, barren planet into a thriving home for countless organisms. So, when we think about the origins of life on Earth, we owe a big thank you to these space-traveling microbes! To create this piece of agar art, first, we filled a 6 cm Petri dish with Simmons citrate culture medium and placed it in the center of a 15 cm Petri dish. Then, we filled the larger Petri dish with Eosin methylene blue culture medium. We used Klebsiella pneumonia for the Earth and Escherichia coli for DNA. K. pneumonia uses citrate and turns the green color of Simmons citrate into blue. E. coli colonies grow with a metallic sheen with a dark center on EMB.
3rd Place
Space Colonization

Kids Category
1st Place
The Rocket Bear
My piece represents a tardigrade outside of a rocket ship. One thing I find interesting about this topic is that tardigrades can live in any environment. The bacteria that I used to create my art is Sarcina aurantiaca. The thing I used to apply the bacteria to the agar was a little circle. It took 1 day for the agar to start growing.
2nd Place (tie)
One Small Step for Tardigrades!

2nd Place (tie)
Playing in the Space
Miscellaneous Contest Entries
Interested in Using an Agar Art Image?
Thanks to this year's judges!
Allison Granberry
André Barbet
Andrés E. Marcoleta
Ashley Hagen
Balaram Khamari
Basanti Dalai
Camilo Berríos-Pastén
Christine Marizzi
Daniel Pham
David Rangel Castro
Diane Flayhart
Didem Rodoplu
Fiza Sikandar
Frank Tran
Girish Mahajan
Jasmine Temple
Joanne Dungo
Joanne Touchberry
Joaquín Acosta
Juan Carlos Elizalde
Judy Nguyen
Kim Xiong
Kosar Ali
Kristen Engevik
Linta Khalid
Lynda Carter
Maria Inda
Laura Echarren
Maria Penil
Marianne Michel
Mary Marinaro
Martyna Pietrzak
Mike Taveirne
Mireya Duran
Mohamadiya Rizwana
Natascha Varona
Norbert Hopf
Riley Cutler
Sarah Adkins-Jablonsky
Shanmuga Priya
Sonja Borndörfer
Valeri Sáenz Moncaleano
Zahir Islam
Ariana Gestal-Gurr
Aziliz C Pernet
Casey Harelik
Ethan Lin
Kate Lin
Manal Faisal Khan
Xinyu Lin
Twitter Feed #AgarArt
{{ result.UserName }} @{{ result.UserScreenName }}
{{ result.Text }}